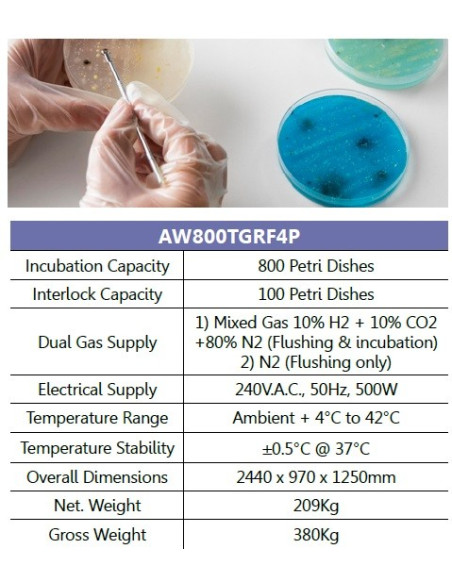
Munro AW800TGRF4P Câmara Anaeróbica/Estação de Trabalho: 4 luvas, para 800 placas de Petri

Munro AW800TGRF4P Câmara Anaeróbica, 4 luvas, para 800 placas de Petri
Câmara Anaeróbica/Estação de Trabalho:
◆ Esta estação de trabalho anaeróbica AW800TGRF4P é a maior estação de trabalho da nossa linha Electrotek.
◆ Uma das principais vantagens desta unidade é que, apesar de sua grande capacidade, ocupa apenas uma modesta área de bancada.
◆ A estação de trabalho é muito econômica de operar, pois são usados dois suprimentos de gás.
O AW800TGRF4P incuba confortavelmente até 800 placas de Petri e vem completo com catalisador e porta-pratos.
► 4 Luvas
► 800 placas de Petri
Operação sem luvas:
► Nosso método exclusivo de mão nua é muito simples de operar; as vedações herméticas se ajustam ao redor dos pulsos dos usuários, conforme mostrado, e a atmosfera anaeróbica é mantida.
► O design elimina o uso de pedais e elimina as grandes tampas das portas internas, proporcionando muito mais espaço de trabalho dentro da incubadora.
► Este sistema também é muito econômico no uso de gás.
► Capacidade de Incubação: 800 Placas de Petri
► Capacidade de bloqueio: 100 pratos de Petri
► Fornecimento de Gás Duplo:
1) Gás misto 10% H2 + 10% CO2 +80% N2 (lavagem e incubação)
2) N2 (somente lavagem)
► Alimentação Elétrica: 240V.A.C., 50Hz, 500W
► Faixa de temperatura: Ambiente + 4°C a 42°C
► Estabilidade de temperatura: ±0,5°C a 37°C
► Dimensões gerais: L = 2.064 mm, D = 660 mm, A = 660 mm
.jpg)
MUNRO-Estações de Trabalho Anaeróbicas para Laboratórios Microbianos.
MUNRO INSTRUMENTS, um fabricante com sede no Reino Unido de câmaras anaeróbicas de alta qualidade para laboratórios microbianos em Hospitais, Institutos e Universidades.
- Instrumento para:
- Hospitais, Lab's, Clínicas
- Função:
- Câmaras Anaeróbicas